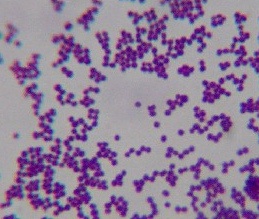

![]()
.
Coccoid
Forms Of Bacteria & By Alan Cantwell, MD
|
Modern medical science recognizes the bacterial cause of tuberculosis, leprosy, syphilis, plague, cholera, as well as the viral cause of new diseases like AIDS and Ebola. Yet, we still dont know the cause of cancer, like breast cancer, prostate cancer, lymphoma, and others. Are we missing something here? Ever since the end of the nineteenth century, there has been a small but persistent group of researchers who claim that pleomorphic bacteria are the unrecognized infective agent of cancer. (Pleomorphism is the ability of certain bacteria to appear in more than one form.) Although these cancer microbes have been carefully studied, almost all doctors firmly reject bacteria as playing any significant role in cancer. Could cancer-causing bacteria go largely unrecognized for more than a century? Could a small group of cancer microbe researchers be correct and cancer experts wrong? Actually, the history of medical science reveals its entirely possible for one doctor to be right and everyone else wrong! In 1940, utilizing a special tissue stain, physician A. Stone Freedberg (1908-2009) found bacteria in patients with stomach ulcers. At the time, physicians believed that ulcers were caused by stress and diet and that bacteria could not thrive in the acid environment of the stomach. Unfortunately, Freedberg could not grow these bacteria and his discovery was not confirmed. Discouraged, he discontinued his studies. Sixty-five years later, a Nobel Prize was awarded to Australian doctors for proving that bacteria (Helicobacter pylori) could cause stomach ulcers, which sometimes lead to stomach cancer. Helicobacter is pleomorphic, existing in both a rod (bacillus) form and a small round coccus form. I became involved in the microbiology of cancer more than 50 years ago when I encountered extremely pleomorphic and impossible-to-classify acid-fast tuberculosis-like bacteria in scleroderma. Through this research I met my mentor Virginia Wuerthele-Caspe Livingston, who was the first physician to discover TB-like mycobacteria in this disease in 1947. This led her into cancer bacterial research, and she became (along with her co-workers) a leading proponent of the cancer microbe theory. Through this small group of researchers, I learned about pleomorphic cell wall-deficient bacteria and their various appearances in tissue (in vivo) and in the laboratory (in vitro). In medical school I had been taught nothing about this. These researchers showed the cancer germ could vary in size and shape and sometimes appear as more than one kind of species of microbe in the laboratory. Extreme pleomorphism in bacteria is often regarded as scientific heresy by microbiologists because they believe that common bacteria reproduce by simply dividing in half. The idea of a cancer germ transforming into different appearances (and even species), depending on how it is grown in laboratory culture, is considered preposterous by many microbiologists. (For more on the cancer bacteria controversy and pleomorphism, see Extreme pleomorphism and the bacterial life cycle, by Milton Wainwright, posted on-line.) Livingston discovered the microbe could be detected in tissue and recognized in culture by use of the acid-fast stain, used since the 19th century for the detection of acid-fast (red-stained) rod forms of tuberculosis bacteria. The cancer microbe was found not only in cancer, but in certain other non-cancerous inflammatory diseases as well. In my later tissue studies of non-cancerous diseases (lupus, scleredema, sarcoid, vasculitis) and cancer (breast cancer, Hodgkins and non-Hodgkins lymphoma, prostate cancer, classic Kaposis sarcoma, and AIDS-associated cancer), I frequently encountered small round coccoid forms that could be seen both inside cells (intracellular) and outside cells (extracellular). These granular forms were usually weakly acid-fast (magenta-colored) or non-acid-fast (blue-stained). They were never noted on the pathologists tissue report, because they did not appear or stain as typical red-stained acid-fast TB-like rod forms of mycobacteria. The routine stain used by pathologists in their tissue work does not stain these bacteria. This report concerns variably-sized, staphylococcus-like forms in cancerous tissue, and provides a possible explanation for how these forms can be overlooked or ignored as cancer-causing agents. As Dr. Freedberg has taught us, bacteria can still pop up in diseases in which they were totally overlooked for decades. Here are eight observations and characteristics of pleomorphic bacteria that exist undetected in cancer. And 12 photographs illustrating how they appear in tissue in vivo and in laboratory culture in vitro.
Characteristics of the cancer coccoid forms in vivo and in vitro1) Microscopic examination of cancerous tissue studied at the highest power (magnification, x 1000, in oil) reveals variably-sized round-shaped coccoid forms of bacteria. These forms frequently resembles the size and shape of ordinary cocci, such as staphylococci. The coccoid forms in cancer are found both within cells and outside of cells. 2) These microbial forms are stained by the acid-fast stain, frequently used to detect mycobacteria like Mycobacterium tuberculosis. However, coccoid forms are frequently non-acid-fast (blue-stained). They are also stained with the Giemsa stain, used to detect microbes. The coccoid forms do not stain well with the Gram stain the stain commonly employed to detect bacteria. They are not stained with the routine stain used by pathologists. 3) The round forms can vary in size from barely visible granules, up to the larger size of yeast and fungal-like spore forms. Occasionally, one can observe large bodies which can attain the size of red blood cells or even larger. This pleomorphism and the inability of these coccoid forms to stain with routine tissue stains suggest they exist in vivo as cell wall deficient (CWD) bacterial forms. Laboratory research of CWD bacteria and CWD mycobacteria has shown that such forms are filterable, passing through standard bacteriologic filters like viruses do. These filterable, submicroscopic virus-like forms are sometimes referred to as mycoplasma. (For more on CWD forms, Google Demystifying pleomorphic forms, by Gerald J Domingue) 4) Large body forms of CWD bacteria in tissue are similar, if not identical, to what pathologists call Russell bodies. However, pathologists consider them non-microbial accumulations of immunoglobulins (protein antibodies). William Russell, a Scottish pathologist, first reported these forms in 1890 as the parasite of cancer. He also encountered similar parasites in tuberculosis and leprosy and skin ulcerations. For more details about their proposed infectious nature, see my article The Russell body: The forgotten clue to the bacterial cause of cancer, posted online. Recently a new rare pathologic tissue abnormality has been described entitled Russell body gastritis, associated with Helicobacter microbial infection of the stomach. 5) Various bacteria in the CWD form can appear similar in morphologic appearance. Therefore, it is impossible to identify the type species until CWD bacteria regain their cell wall and revert to well-defined forms in laboratory culture. Some CWD bacteria are unable to revert to the parent form. Tedeschi and his co-workers have found that normal human blood harbors CWD bacteria, identified as staphylococcus, streptococcus and corynebacteria-like microbes, some of which were acid-fast. 6) These intra- and extracellular coccoid forms consistently observed in acid-fast stained cancerous tissue are not contaminants. They are not secondary invaders because they can be observed in precancerous inflammatory conditions before cancer is initiated. Various species of bacteria have been grown from cancer and non-cancerous tissue in which "coccoid forms" were noted in vivo. In my experience, skin biopsy specimens sent for culture have been identified as Staphylococcus epidermidis, "coccobacilli" in the form of corynebacteria ("diphtheroids") and sometimes Propionibacterium acnes. Very rarely have acid-fast mycobacteria been grown from scleroderma and AIDS-associated "immunoblastic lymphoma." After extensive investigation, one isolate from a scleroderma patient was finally identified as a Micromonospora species; another patients isolate as Mycobacterium fortuitum. 7) According to reports from various cancer microbe researchers, careful culture of cancerous tissue also reveals a variety of pleomorphic and common bacteria, such as staphylococci, streptococci, coccobacillary (cocci and rod) forms, and rarely acid-fast myobacteria. Of particular interest is the controversial mycococcus form of mycobacteria, apparently indistinguishable from ordinary staphylococci, reported by Anna Csillag in 1964 and available online. Observed over a period of time and on different lab growth media, these various microbes tend to transform between cocci and coccobacillary forms. Such unprecedented transformations, along with intermittent acid-fastness, seem to defy the rigid laws of bacteriology. Specific species identification depends on stable lab culture characteristics, and bacteria isolated from cancer tend to be unstable and difficult to classify. In addition, bacterial cultures from cancer are often quickly identified and ignored as simple and common species, and/or universally regarded as contaminants of no import. This is why the primordial coccoid form in vivo is so important to recognize. It is neither a contaminant nor a secondary invader. These forms are the key to uncovering the CWD bacteria hiding in cancer. 8) How can these coccoid forms remain undetected when every doctor who hunts for TB bacteria in tissue has undoubtedly encountered them? Physicians dont believe bacteria cause cancer, so perhaps there is no interest in searching for them in specially-stained tissue sections painstakingly examined under oil immersion. Another reason is that some closely-packed groups of intracellular coccoid forms and granules bear a slight resemblance to mast cells, a common tissue cell with a nucleus and a cytoplasm jam-packed with tiny granules. Thus, some researchers have rejected all reported coccoid forms in cancer as mast cells; and consider the extracellular coccoid forms as liberated mast cell granules. But unlike mast cell granules, the larger coccoid forms are much larger in size. And, most importantly, mast cell granules never attain the very large size of CWD bacterial large bodies or Russell bodies. (For Internet images of mast cells, Google: mast cell x1000 in connective tissue.) Bacteria, Cancer, and the human microbiome With the dawn of the 21st century there is now a realization that the human body is essentially a superorganism. Ninety percent of the cells in the body are microbial cells and most of these cells are bacteria. They undoubtedly play a major role in human health, but little is known about their role in cancer, chronic disease, and aging. The precise relationship of the coccoid forms in cancer to body bacteria is also not known. When Livingston classified her pleomorphic cancer microbe as Progenitor cryptocides in 1970 and proposed a bacterial vaccine, she was severely criticized for promoting a microbe that did not exist in the scientific world. Some colleagues called her a quack, a term she was labeled with until her death in 1990. At present, it still seems premature to argue about what species to "call" these pleomorphic cancer-associated bacteria. More important is to have agreement as to whether these CWD coccoid bacterial forms exist (or do not exist) in cancerous tissue. After this is accomplished, investigators can argue about what species are involved, and how these microbes initiate the cellular and genetic changes characteristic of cancer. LEGEND FOR PHOTOGRAPHS
Figure 1. Smear from culture of Staphylococcus epidermidis commonly cultured from human skin. Compare the uniform size and shape of these typical cocci with the coccoid forms seen in the tissue photos below and with the cocci isolated in culture from cancer. Gram stain, x1000, in oil. (Internet photo provided by Divya Ravinder, www.modmedmicrobes.wikispaces.com)
Figure 2. Unclassified pleomorphic bacteria isolated from the skin of scleroderma. The red-stained rod forms in the center are acid-fast; the non-acid-fast blue-stained cocci are staphylococcus-like. Repeat culture at death revealed an acid-fast organism identified as Mycobacterium fortuitum. Ziehl-Neelsen (acid-fast) stain, x1000, in oil.
Figure 3. Tissue section from breast cancer showing a clump of non-acid-fast, blue-stained coccoid forms. Fite (acid-fast) stain, x1000, in oil.
Figure 4. Staphylococcus epidermidis cultured from breast cancer metastasis to the skin. Note the resemblance of these cocci to the coccoid forms in vivo pictured in the original breast cancer tissue. Gram stain, x1000, in oil.
Figure 5. AIDS-associated enlarged lymph node showing non-specific hyperplasia and intracellular small coccoid forms (arrow) and nearby large extracellular Russell bodies (large bodies). Fite (acid-fast) stain, mag x1000, in oil.
Figure 6. Same tissue section as Figure 5. from an enlarged lymph gland showing non-specific hyperplasia in an AIDS patient. Note the transition of the extracellular (A) and intracellular coccoid forms (B-D) into progressively larger Russell bodies (E-J) and giant Russell bodies (K-L). Giemsa stain A-G,L. Fite stain H; Gram stain K,L. x1000, in oil.
Figure 7. Tissue section of AIDS-related Kaposis sarcoma of the skin showing a collection of coccoid forms in the dermis. Giemsa stain, x1000, in oil. Insert shows Staphylococcus epidermidis cultured from the lesion. Gram stain, x1000.
Figure 8. Tissue section from Hodgkins lymphoma of a lymph node showing a solitary giant, large body or Russell body. Gram stain, x1000, in oil.
Figure 9. Tissue section of AIDS-related immunoblastic sarcoma of the skin. Non-acid-fast coccoid forms are seen in A-C. Three extremely rare acid-fast rods are seen in D. Fite stain, x1000, in oil.
Figure 10. Color photo of same rods (bacilli) illustrated in Figure 9D. The acid-fast rods are red-stained. Mycobacterium avium-intracellulare was cultured from the tumor.
Figure 11. Smear of Mycobacterium avium-intracellure cultured from immunoblastic lymphoma. Pleomorphic forms consist of acid-fast rod forms and arrows point to blue-stained non-acid-fast cocci. Compare the size and shape of these cocci to the coccoid forms seen in the tissue sections in Figure 9 A-C. Ziehl-Neelsen (acid-fast) stain, mag x1000, in oil.
Figure 12. Tissue section from prostate cancer. A clump of coccoid forms on the right; and extracellular forms in the stroma on the left. Fite stain, x 1250, in oil.
BIBLIOGRAPHY: Andersen LP, Rasmussen L (2009) Helicobacter pylori-coccoid forms and biofilm formation. FEMS Immunol Med Microbiol 56:112-115 Beran V, Havelkova M, Kaustova J, et al. (2006) Cell wall deficient forms of mycobacteria: A review. Veterinarni Medicina 51:365-389 Broxmeyer L (2004) Is cancer just an incurable infectious disease? Med Hypotheses 63:986-996 Cantwell A (1980) Histologic forms resembling large bodies in scleroderma and pseudoscleroderma. Amer J Dermatopathol 2:273-276 Cantwell A, Kelso D (1981) Microbial findings in cancer of the breast and in their metastases to the skin. J Dermatol Surg Oncol 7:483-491 Cantwell A (1982a) Variably acid-fast cell wall-deficient bacteria as a possible cause of dermatologic disease. In: Domingue GJ (ed) Cell wall deficient bacteria. Reading, Addison-Wesley Publishing Co, Pp. 321-360 Cantwell A, Rowe L (1985) African "eosinophilic bodies" in vivo in two American men with Kaposi's sarcoma and AIDS. J Dermatol Surg Oncol 11:408-12 Cantwell A (1986) Mycobacterium avium-intracellulare infection and immunoblastic sarcoma in a fatal case of AIDS. Growth 50:32-40 Cantwell A (1990) The Cancer Microbe. Los Angeles, Aries Rising Press Diller IC, Diller WF (1965) Intracellular acid-fast organisms isolated from malignant tissues. Trans Amer Micr Soc 84:138-148 Domingue GJ, Schlegel JU (1977) Novel bacterial structures in human blood: cultural isolation. Infect Immun 15:621-7 Hess, D (1997) Can bacteria cause cancer? New York University, Press, New York Kajander EO, Tahvanainen E, Kuronen I, et al, (1994) Comparison of staphylococci and novel bacteria-like particles from blood. Zbl Bakt Suppl 26 Licci S, Sette P, Del Nonno, F, et al. (2009) Ciarletti S, Antinori A, Morelli L. Russell body gastritis associated with Helicobacter pylori infection in an HIV-positive patient: case report and review of the literature. Z Gastroenterol 47: 57-60 Malhotra S, Bhatia N, Kaushal M, et al. (2010) Case report: Pleomorphic appearance in Mycobacterium tuberculosis. J Pub Health Epidemiol 2:11-12 Mattman L (1993) Microbes and malignancy. In: Mattman L. Cell wall deficient forms: Stealth pathogens. (Ed2), CRC Press, Boca Raton McLaughlin RW, Vali H, Lau PC, et al. (2002) Are there naturally occurring pleomorphic bacteria in the blood of healthy humans? J Clin Microbiol 40:4771-5 Nuzum JW (1925) The experimental production of metastasizing carcinoma of the breast of the dog and primary epithelioma in man by repeated inoculation of a micrococcus isolated from human breast cancer. Surg Gynecol Obstet 11:343-352 Russell W (1890) An address on a characteristic organism of cancer. Br Med J 2:1356-1360 Russell W (1899) The parasite of cancer. Lancet 1:1138-1141 Seibert FB, Yeomans F, Baker JA, Davis RL, Diller IC (1972) Bacteria in tumors. Trans N Y Acad Sci 34:504-533. Tedeschi GG, Amici D, Sprovieri G, et al. (1976) Staphylococcus epidermidis in the circulating blood of normal and thrombocytopenic human subjects: immunological data. Experientia 32:1600-2 Wainwright M (1997) Extreme pleomorphism and the bacterial life cycle: A forgotten controversy. Perspectives in Biology and Medicine 40:407-414 Wainwright M (2000) Highly pleomorphic staphylococci as a cause of cancer. Med Hypotheses .2000 54:91-4 Wuerthele-Caspe Livingston V, Alexander-Jackson (1970) A specific type of organism cultivated from malignancy: Bacteriology and proposed classification. Ann N Y Acad Sci 174:636-654 Wuerthele-Caspe Livingston VW, Livingston AM (1974) Some cultural, immunological, and biochemical properties of Progenitor cryptocides. Trans NY Acad Sci 36:569-582 Young J (1921) Description of an organism obtained from carcinomatous growths. Edinburgh Med J 27:212-221 [Dr. Cantwell is a retired dermatologist. He is the author of The Cancer Microbe, and Four Women Against Cancer, both available through amazon.com. Abstracts of his medical journal publications can be found on the PubMed website (type-in Cantwell AR). His Internet writings on the microbiology of cancer are posted on the joimr.org website and on rense.com.] |
| Donate
to Rense.com
Support Free And Honest
Journalism At Rense.com |
Subscribe
To RenseRadio!
Enormous Online Archives,
MP3s, Streaming Audio Files,
Highest Quality Live Programs |